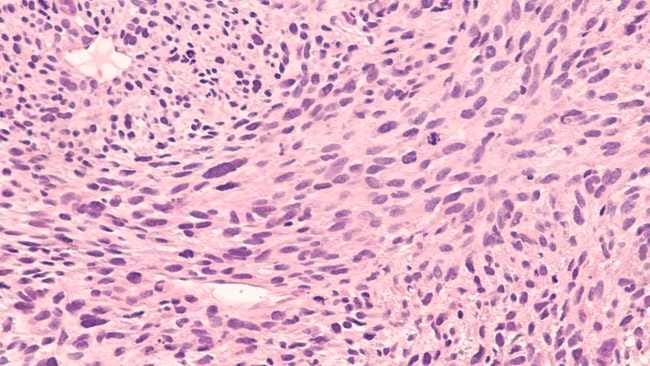
Kanker Jaringan Lunak, Kenali Gejala, Penyebab, dan Penanganannya - Alodokter

Kanker jaringan lunak adalah kanker langka yang tumbuh pada jaringan penopang tubuh, seperti otot, lemak, pembuluh darah, saraf, tendon, atau jaringan sekitar sendi. Pada awalnya, gejala yang timbul sering tidak khas, tetapi kanker ini bisa cepat berkembang dan berbahaya jika dibiarkan tanpa penanganan.
Kanker jaringan lunak sering berkembang tanpa gejala yang khas pada awalnya, sehingga banyak kasus baru terdeteksi saat kondisi sudah parah. Umumnya, penyakit ini lebih berisiko terjadi pada orang yang sering terpapar radiasi, memiliki kelainan genetik, atau sering bersentuhan dengan bahan kimia tertentu.
Selain itu, gejala yang ditimbulkan dapat berupa benjolan jinak atau cedera ringan, sehingga terkadang sulit dikenali sejak dini. Dengan mengenali kanker jaringan lunak, Anda bisa lebih cepat menyadari gejala yang mencurigakan.
Gejala Kanker Jaringan Lunak yang Perlu Diwaspadai
Pada tahap awal, gejala kanker jaringan lunak sering kali tidak spesifik atau bahkan tidak terasa. Namun, seiring berkembangnya penyakit, beberapa tanda berikut bisa muncul dan perlu diwaspadai:
- Muncul benjolan yang terus membesar
- Benjolan biasanya tidak terasa sakit pada awalnya, tetapi lama-lama bisa menekan jaringan sekitar hingga menyebabkan nyeri
- Nyeri di area benjolan, terutama jika tumor menekan saraf atau organ di sekitarnya
- Sulit bergerak atau bengkak, terutama bila kanker tumbuh di sekitar sendi, tangan, atau kaki
- Penurunan berat badan tanpa sebab
- Mudah lelah, sering merasa lemas atau tidak bertenaga
Penyebab dan Faktor Risiko Kanker Jaringan Lunak
Hingga kini, penyebab pasti kanker jaringan lunak belum diketahui secara jelas. Namun, beberapa faktor berikut dapat meningkatkan risiko seseorang mengalami kanker jaringan lunak:
1. Paparan radiasi
Paparan radiasi tinggi merupakan salah satu faktor yang dapat meningkatkan risiko kanker jaringan lunak. Umumnya, orang yang pernah menjalani radioterapi dalam pengobatan kanker lain diketahui memiliki kemungkinan lebih besar untuk mengembangkan kanker jaringan lunak di area yang telah terpapar.
Sebab, radiasi tersebut dapat menyebabkan perubahan pada struktur DNA sel, sehingga sel tumbuh tidak terkendali dan membentuk tumor ganas. Oleh karena itu, penting untuk memantau kondisi kesehatan secara berkala jika Anda memiliki riwayat paparan radiasi dalam jangka panjang.
2. Kelainan genetik
Kelainan genetik tertentu, misalnya sindrom Li-Fraumeni atau neurofibromatosis, diketahui dapat meningkatkan risiko kanker jaringan lunak. Mutasi pada gen tertentu membuat sel-sel tubuh lebih rentan berubah menjadi sel kanker, termasuk pada jaringan penyangga seperti otot dan lemak.
Umumnya, orang dengan riwayat keluarga yang pernah mengalami kanker jaringan lunak juga berpeluang tinggi untuk terkena penyakit ini.
3. Paparan bahan kimia tertentu
Paparan jangka panjang terhadap bahan kimia berbahaya, seperti herbisida, pestisida, vinyl chloride, dan dioxin, juga dikaitkan dengan peningkatan risiko kanker jaringan lunak. Hal ini karena zat kimia tersebut dapat masuk ke dalam tubuh melalui saluran pernapasan atau kulit yang menimbulkan perubahan pada sel jaringan lunak.
Orang yang bekerja di lingkungan industri kimia atau pertanian berisiko lebih tinggi mengidap kanker jaringan lunak jika tidak menggunakan perlindungan yang memadai.
4. Cedera atau luka lama yang tidak sembuh
Cedera atau luka lama yang tidak kunjung sembuh kadang dikaitkan dengan munculnya kanker jaringan lunak. Namun, hal ini jarang terjadi dan belum ada bukti kuat yang memastikan keterkaitannya. Meski begitu, gangguan proses penyembuhan diduga dapat memicu pertumbuhan sel yang tidak normal di area tersebut..
Bahkan, pada kondisi tertentu, sel-sel jaringan lunak di sekitar luka dapat mengalami perubahan genetik akibat proses peradangan kronis, sehingga meningkatkan risiko munculnya kanker jaringan lunak. Oleh karena itu, bila Anda memiliki luka yang sulit sembuh disertai pembengkakan, segera periksakan diri ke dokter, ya.
5. Usia dan faktor keturunan
Risiko kanker jaringan lunak cenderung meningkat seiring bertambahnya usia. Orang dewasa, terutama di atas 50 tahun, lebih sering didiagnosis dengan kanker jaringan lunak dibandingkan dengan anak-anak.
Selain itu, faktor keturunan juga berperan penting, terutama jika terdapat anggota keluarga dekat yang pernah menderita kanker jaringan lunak. Dengan mengetahui adanya riwayat keluarga ini, dokter dapat memberikan saran pemeriksaan dini agar kanker jaringan lunak dapat dideteksi sejak awal.
Diagnosis dan Penanganan Kanker Jaringan Lunak
Diagnosis kanker jaringan lunak umumnya diawali dengan pemeriksaan fisik untuk menilai benjolan atau gejala yang mencurigakan. Setelah dicurigai tanda-tanda sel kanker, dokter akan menyarankan pasien untuk menjalani pemeriksaan penunjang, seperti USG, MRI, atau CT scan, guna mengetahui lokasi, ukuran, dan karakteristik tumor secara lebih detail.
Selain itu, dokter mungkin akan melakukan biopsi, yaitu pengambilan sampel jaringan dari benjolan untuk diperiksa di laboratorium. Setelah diagnosis ditegakkan, dokter dapat menentukan penanganan terbaik berdasarkan ukuran, lokasi, jenis, serta tingkat keganasan kanker jaringan lunak.
Berikut ini adalah beberapa pengobatan untuk mengatasi kanker jaringan lunak: Operasi
- Radioterapi
- Kemoterapi
- Terapi target
- Rehabilitasi medis
Semakin dini kanker jaringan lunak terdeteksi, peluang keberhasilan pengobatannya akan lebih besar. Oleh karena itu, jangan abaikan benjolan di tubuh yang tidak kunjung hilang atau justru bertambah besar.
Penanganan kanker jaringan lunak umumnya memerlukan kolaborasi dari berbagai dokter spesialis, seperti dokter bedah, onkologi, radioterapis, hingga ahli rehabilitasi medis. Pemantauan ketat dan tindak lanjut secara berkala penting dilakukan agar potensi kekambuhan dan komplikasi dapat ditekan.
Jika Anda atau anggota keluarga menemukan benjolan yang tidak wajar di tubuh, terutama jika semakin besar atau disertai keluhan lain seperti nyeri, sulit bergerak, atau penurunan kondisi tubuh, jangan tunda untuk berkonsultasi ke dokter, ya.
Konsultasi dapat dilakukan di mana saja dan kapan saja serta cepat dan praktis melalui Chat Bersama Dokter di aplikasi ALODOKTER. Dengan begitu, dokter dapat memastikan penyebabnya dan memberikan penanganan sesuai kondisi Anda, termasuk pemeriksaan lebih lanjut di rumah sakit terdekat.